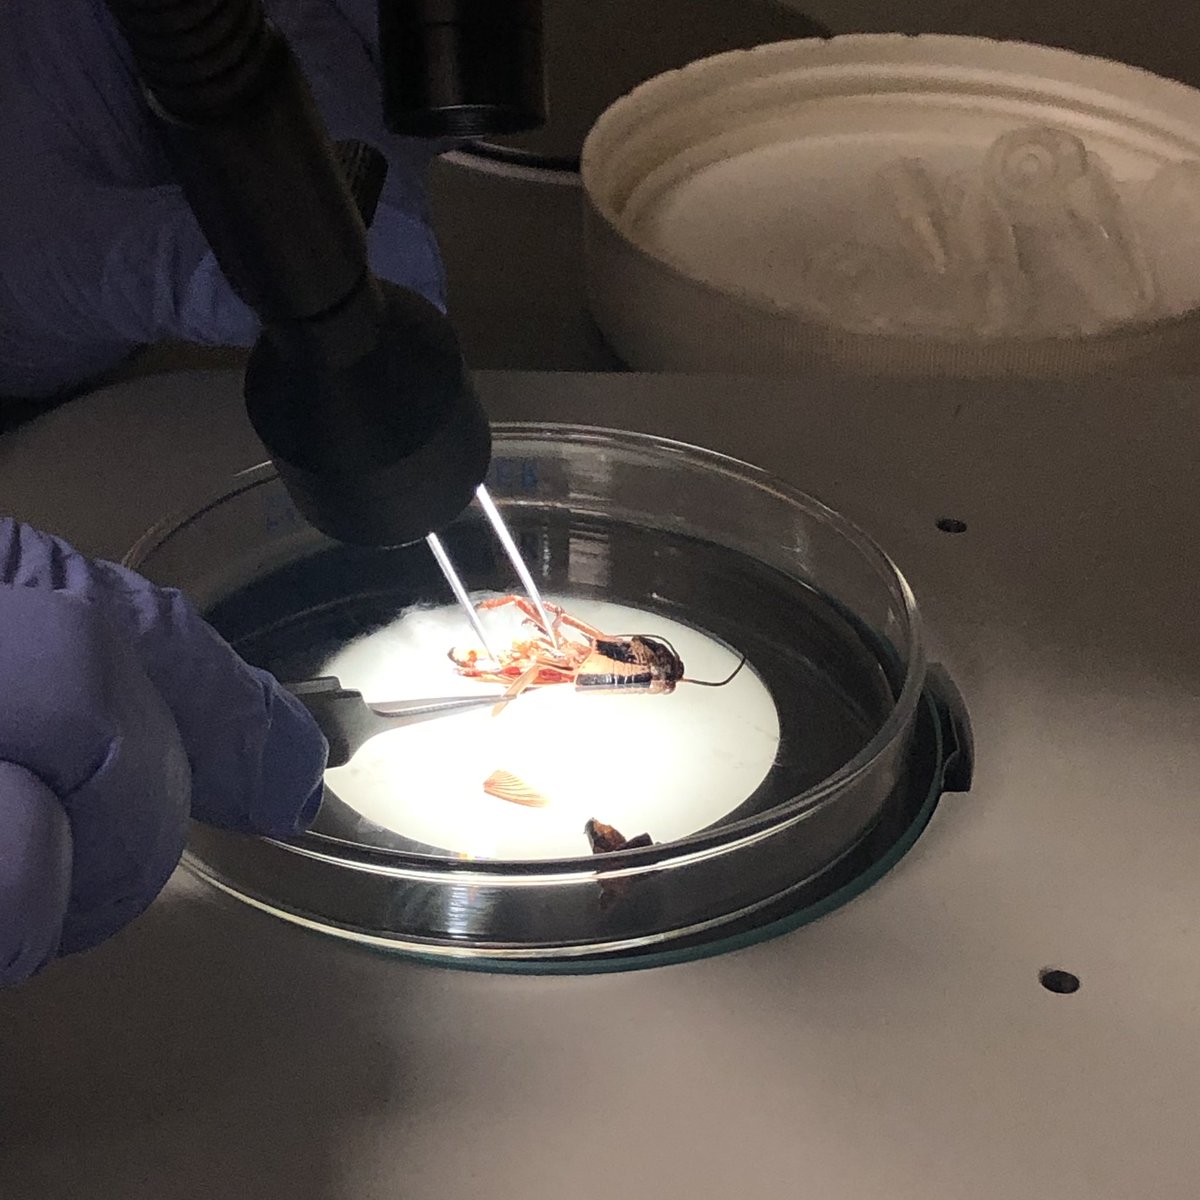
Britt Peterson tweet media

@mstephens1024 Had a great time chatting with you today! May have been the first time but definitely not that last!
English
Britt Peterson
35 posts

@drbugguts
Assistant Professor, Microbial Ecologist, STEM Educator, Insect-Microbe Associations

Excited to announce the launch of @sonoran_data today! We're a small company specializing in personalized data-science services for companies and organizations of all sizes. Check out our project portfolio! bit.ly/2pa58o5 #rstats #r4ds #Python #DataScience
